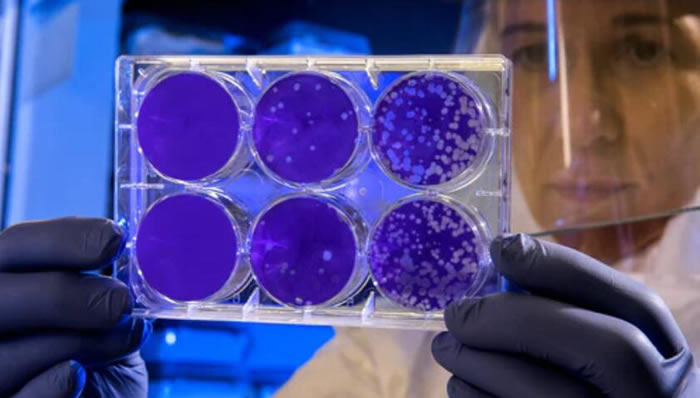
科学家 硅谷Altos Labs的新冒险：通过细胞重编程让人类寿命延长50年

在Palo Alto的洛斯阿多斯山(Los Altos Hills)有一幢大楼 , 它属于大富豪尤里·米尔纳(Yuri Milner) 。 去年10月 , 一群科学家来到大楼 。 干什么呢?这群科学家参加为期2天的会议 , 还有许多人通过视频方式参与 。 大家讨论主题很有意思:如何利用生物技术让人年轻起来?
米尔纳是俄罗斯富豪 , 他曾向Facebook、Mail.ru投资 , 赚了不少钱 。 受到会议的推动 , 他们成立一家野心勃勃的新公司 , 名叫Altos Labs 。 Altos Labs的目标是推动生物重编程技术向前发展 , 这种技术可以在实验室让细胞恢复活力 。 一些科学家认为利用该技术可以让整个身体恢复活力 , 从而延长人类寿命 。
新公司年初时在美国、英国注册 , 未来会在湾区、San Diego、英国、日本等地设立分支 。 Altos Labs拿出丰厚的薪酬吸引大学科学家 , 还向科学家承诺他们可以无拘无束研究细胞老化原理 , 寻找逆转方法 。 就连亚马逊创始人贝佐斯就是新公司的投资者之一 。
Altos Labs与 Calico Labs可以拿来对比 。 Calico Labs是2013年成立的 , 创建者是谷歌联合创始人佩奇 。 Calico也招募了大批科学家 , 只是人们一直怀疑它到底取得多少进展 。 Calico也对细胞重编程技术很重视 。
到底有哪些知名科学家加入Altos Labs呢?西班牙发育生物学家胡安·卡洛斯·伊兹皮索阿·贝尔蒙特(Juan Carlos Izpisúa Belmonte)是其中之一 , 他正在研究如何将人类和猴子的胚胎混合 。 按照贝尔蒙特的预测 , 人类寿命可以增加50年 。 还有加州大学洛杉矶分校教授Steve Horvath和Shinya Yamanaka 。 2012年Shinya Yamanaka因为在细胞重编程方面取得突破拿到诺贝尔奖 。
Shinya Yamanaka有一个重大发现:只需要添加四种蛋白质(现在叫Yamanaka因子) , 细胞可以被指示恢复到具有胚胎干细胞特性的原始状态 。 到2016年Salk实验室已经将这些因子应用于完整的活老鼠 , 出现了年龄逆转的迹象 。 但结果同样让人害怕 。 根据重组发生的程度 , 一些老鼠患上畸胎瘤 , 而另一些老鼠则显示出组织变得更年轻的迹象 。
Yamanaka在电子邮件中表示:“虽然有很多困难要克服 , 但潜力是巨大的 。 ”他承认自己在Altos Labs担任重要职位 。
中年危机
有人说:“年轻人向往富有 , 富人向往年轻 。 ”还真是一点不假 。 米尔纳已经59岁 , 身家48亿美元;贝佐斯57岁 , 身家约为2000亿美元 。
知情者称 , 最开始之所以创建Altos目的很单纯 , 因为米尔纳认为细胞重编程是慈善 。 最初一个名为Milky Way Research Foundation的基金会拿到了米尔纳的资助 , 向几名长寿研究人员提供支持 。 到了2021年一个新计划浮出水面 , 它的目标是让项目加速发展 , 于是大家便成立了Altos公司 。
对细胞重组技术有兴趣的不只有Altos , 还有Life Biosciences、Turn Biotechnologies、AgeX Therapeutics、Shift Bioscience 。 它们虽然在努力 , 但至今没有机构在临床时对任何人实验过 。
去年12月 , 哈佛研究人员David Sinclair用细胞重编程技术恢复了老鼠的视力 , 他说:“投资者已经向细胞重编程投了不少钱 , 主要目标是让人类身体的部分或者整体恢复活力 。 ”
Sinclair认为这一领域有独特前景 , 他的实验室关注主要器官和组织 , 比如皮肤、肌肉和大脑 , 想看看能否让它们恢复活力 。
科学与生意
有人估计 , Altos实验室至少已经融资2.7亿美元 , 投资者包括贝佐斯、米尔纳 , 可能还有一些科技富豪和VC投资 。 Altos向研究人员提供资金支持 , 但不会要求他们在短期内拿出产品或者创造营收 。
Altos给大学教授开出的薪酬很高 , 每年约为100万美元甚至更多 , 还会授予股权 , 申请拨款也没有那么麻烦 。 西班牙巴塞罗那生物医学研究所的Manuel Serrano说 , 他已经拿到实验室职位 , 实验室开出的薪酬是他目前收入的5-10倍 。
Manuel Serrano准备前往英国剑桥 , 那里有Altos的分支机构 。 Manuel Serrano表示:“Altos的哲学就是做一些以好奇作为驱动的研究 。 这正是我擅长和喜欢的 。 虽然它是一家私营公司 , 但我们在探索时很自由 。 ”
针对衰老的治疗方式如果有效 , 价值当然是极高的 , 财富会滚滚而来 , 但Altos最开始考虑的并不是赚钱 。 Manuel Serrano说:“目标是深入理解返老还童 。 未来会获得营收 , 但营收在目前不是迫切目标 。 ”
2013年时一批科学家改造老鼠 , 使之产生Yamanaka因子 , Manuel Serrano正是参与者之一 。 虽然老鼠生成了肿瘤 , 但实验还是告诉我们生物的衰老是可逆的 。 Manuel Serrano说:“引入因子 , 它们就会展示魔力 。 实验很简单 , 只是还没法理解 。 ”
推荐阅读
- 揭秘陶乐德事件:男子在拘留室离奇消失,难道平行时空真的存在?
- 青藏高原将停止增高,后果不可承受,我们却未感到危机
- 寻求气候变化的确定性:要多少才足够?
- 少见!今年十五的月亮,不是十六圆
- 科学家在大型强子对撞机上寻找难以捉摸的基本粒子
- 地球果真出了大问题?火山爆发后出现神秘现象,科学家紧急发声
- 简述相对论发展史:从伽利略到引力波
- 重磅!英美科学家对奥密克戎病毒11个最新判断!对全球意义重大!
- 15000年前海底金字塔被发现,科学家推测:中华文明前身是MU文明
- 人的气运竟然真的存在?科学家竟然已经证实!







